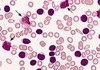
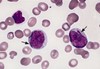
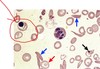
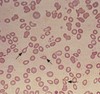
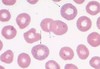
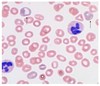
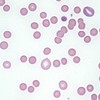
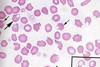
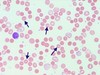
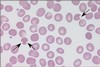

Blood film Flashcards
(24 cards)
Smudge cells
CLL
Hairy Cell

= Hairy cell leukaemia
Auer rods
= AML
Red Cell Ghosts (black arrows)

Red Cell Ghosts - RBCs w/o Hb indicate intravascular lysis
Associations
-fulminant bacterial infections eg clostridium perfringens
Normocyte/Nucleated RBC
Not normal in peripheral blood
Association - severe haemolysis, hypoxaemia, myelofibrosis
Reticulocytes

Reticulocytes
Normally 1% of blood film
Increased when RBC turnover and creation is high - bleeding, haemolysis
Decreased when BM is suppressed - aplastic anaemia, systemic chemo
Teardrop/Dacrocyte
Associations - signify extramedullary haematopoiesis
- *- primary myelofibrosis**
- thalassaemia
Dohle Bodies

Associations
- infection
- inflammation
Hypersegmented neutrophil (>5 lobes)

Association
- Megaloblastic anaemia (B12, Folate)
- Rarely, iron deficiency anaemia
Rouleaux Formation

Associations:
- Infection
- *- Multiple myeloma**
- Waldenstrom’s macroglobulinemia
- Inflammatory and connective tissue disorders
- Malignancy
- *- DM** (a causative factor for microvascular occlusion in diabetic retinopathy)
Basophilic Stippling
Associations
- Toxic injury to BM, such as lead or heavy metal poisoning.
- Severe anemia
- Thalassaemia
- Alcohol abuse
Polychromasia - premature release of RBCs
Associations
- anaemia, various causes
Spherocytes
Associations
- Warm and cold autoimmune hemolytic anemia
- Acute and delayed hemolytic transfusion reactions
- Hereditary spherocytosis
- Hypophosphatemia
- Bartonellosis
- Snake bite
- Hyposplenism
- Severe burns
Blister Cells - precursor of bite cells (aka basket cells, half-ghost cells)
Associations:
- G6PD deficiency
- Unstable hemoglobins
Stomatocytes
Association:
- Artifact (due to slow drying in humid environment)
- Liver disease
- Alcoholism
- Rh-null disease
- Obstructive lung disease
Bite Cell/Degmacyte
Associations
- *- G6PD deficiency
- Oxidative stress**
- Unstable haemoglobins
- Congenital heinz body anaemia
Burr Cells

Association
- In-vitro artifact following prolonged storage or slow drying of the smear due to high humidity
- *- Uraemia
- Malnutrition**
Schistocyte

Association = INTRAVASCULAR HAEMOLYSIS
- *- DIC
- TTP
- HUS**
Target Cells

Association
- Sickle cell disease
- Haemoglobin C trait/haemoglobin CC disease
- *- Thalassemias**
- Iron deficiency
- Liver disease (cholestasis)
- Asplenia
Sickle Cell

Association
-Sickle Cell Anaemia
Howell-Jolly Bodies
Associations
- *- Asplenia**
- Other: amyloidosis, severe hemolytic anemia, megaloblastic anemia, hereditary spherocytosis, and MDS
Metamyelocyte
- Cell undergoing granulopoiesis, derived from a myelocyte, and leading to a band cell.
- bent nucleus, cytoplasmic granules, and the absence of visible nucleoli
Pencil Cells
Association
- Iron deficiency
Spur cells/Acanthocytes
Associations:
- Liver disease
- Renal failure
- Abetalipoproteinaemia*
- Spur cell anaemia
- Pyruvate kinase deficiency


